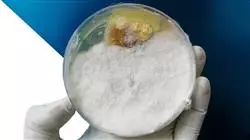
##IMAGE##

Titolo universitario
La più grande facoltà di nutrizione del mondo"
Presentazioni
Questo è il miglior Corso universitario per i nutrizionisti che desiderano crescere e specializzarsi professionalmente nel campo della Parassitologia. Non perdere quest’opportunità, iscriviti”
Questo Corso universitario offre agli studenti interessati alla crescita professionale un approccio specifico sulla Parassitologia e la relativa applicazione nella produzione alimentare, affrontando temi quali gli effetti che questi organismi producono negli alimenti e il loro impatto sulla salute umana. Inoltre, lo studente sarà in grado di assimilare tutti questi concetti e di attuare strategie di mitigazione per questo tipo di rischio.
Il programma comprende anche argomenti relativi all'identificazione e alla gestione dei parassiti nell'industria alimentare, che forniranno tecniche per la loro individuazione, prevenzione e controllo. Verrà inoltre approfondita l'implementazione di buone pratiche di igiene e manipolazione degli alimenti, con l'obiettivo di garantire la sicurezza e la qualità di questi prodotti.
In questo modo, gli studenti potranno ampliare le proprie conoscenze e acquisire una preparazione integrale in questo campo, in modo da essere pienamente qualificati per affrontare le sfide che esistono attualmente nell'Industria Alimentare in termini di sicurezza e qualità degli alimenti.
Tutto ciò, grazie all'innovativa metodologia Relearning, che permetterà allo studente di studiare da casa e di avere una maggiore flessibilità di orario, poiché avrà accesso in ogni momento alle risorse multimediali che troverà nel campus virtuale. Inoltre, gli studenti potenzieranno le proprie e aumenteranno la capacità di risolvere i problemi, analizzando casi pratici che li aiuteranno a collocarsi in uno scenario reale.
Vuoi raggiungere l'eccellenza nel campo della Parassitologia? Iscriviti subito per scoprire come raggiungerla grazie a questa specializzazione”
Questo Corso universitario in Parassitologia nell’Industria Alimentare possiede il programma scientifico più completo e aggiornato del mercato. Le caratteristiche principali del programma sono:
- Sviluppo di casi di studio presentati da esperti in Parassitologia nell’Industria Alimentare
- Contenuti grafici, schematici ed eminentemente pratici in base ai quali sono stati concepiti forniscono informazioni scientifiche e pratiche riguardo alle discipline essenziali per l’esercizio della professione
- Esercizi pratici con cui è possibile valutare sé stessi per migliorare l'apprendimento
- Speciale enfasi sulle metodologie innovative
- Lezioni teoriche, domande all'esperto e/o al tutore, forum di discussione su questioni controverse e compiti di riflessione individuale
- Contenuti disponibili da qualsiasi dispositivo fisso o mobile dotato di connessione a internet
Approfondisci le tecniche di diagnosi dei parassiti alimentari e acquisisci competenze avanzate per interpretare i risultati grazie all'approccio pratico di questo programma"
Il personale docente comprende professionisti del settore, che forniscono agli studenti le competenze necessarie a intraprendere un percorso di studio eccellente.
I contenuti multimediali, sviluppati in base alle ultime tecnologie educative, forniranno al professionista un apprendimento coinvolgente e localizzato, ovvero inserito in un contesto reale.
La creazione di questo programma è incentrata sull’Apprendimento Basato sui Problemi, mediante il quale il professionista deve cercare di risolvere le diverse situazioni di pratica professionale che gli si presentano durante il corso. Lo studente potrà usufruire di un innovativo sistema di video interattivi creati da esperti di rinomata fama.
Seguendo il tuo ritmo e in modo virtuale, potrai approfondire le tue conoscenze in questo settore"

Approfondisci la tua comprensione dei termini essenziali della parassitologia e porta la tua carriera a un livello superiore"
Perché studiare al TECH?
TECH è la più grande università digitale del mondo. Con un catalogo eccezionale di oltre 14.000 programmi accademici disponibili in 11 lingue, si posiziona come leader in termini di occupabilità, con un tasso di inserimento professionale del 99%. Inoltre, dispone di un enorme personale docente, composto da oltre 6.000 professori di altissimo prestigio internazionale.

Studia presso la più grande università digitale del mondo e assicurati il successo professionale. Il futuro inizia con TECH”
La migliore università online al mondo secondo FORBES
La prestigiosa rivista Forbes, specializzata in affari e finanza, ha definito TECH «la migliore università online del mondo». Lo hanno recentemente fatto notare in un articolo della loro edizione digitale che riporta il caso di successo di questa istituzione, «grazie all'offerta accademica, alla selezione del suo personale docente e a un metodo di apprendimento innovativo orientato alla formazione dei professionisti del futuro».
Un metodo di studio dirompente, un personale docente all'avanguardia e il suo orientamento pratico: elementi chiave del successo di TECH.
I piani di studio più completi del panorama universitario
TECH offre i piani di studio più completi del panorama universitario, con argomenti che coprono concetti fondamentali e, allo stesso tempo, i principali progressi scientifici nelle loro specifiche aree scientifiche. Inoltre, questi programmi sono continuamente aggiornati per garantire agli studenti l'avanguardia accademica e le competenze professionali più richieste. In questo modo, i titoli universitari forniscono agli studenti un vantaggio significativo per elevare le loro carriere verso il successo.
TECH dispone dei piani di studio più completi e intensivi del panorama universitario attuale.
Il miglior personale docente internazionale top
Il personale docente di TECH è composto da oltre 6.000 docenti di massimo prestigio internazionale. Professori, ricercatori e dirigenti di multinazionali, tra cui Isaiah Covington, allenatore dei Boston Celtics; Magda Romanska, ricercatrice principale presso MetaLAB ad Harvard; Ignacio Wistumba, presidente del dipartimento di patologia molecolare traslazionale di MD Anderson Cancer Center; o D.W Pine, direttore creativo della rivista TIME, ecc.
Esperti di livello internazionale, specializzati in diversi settori in materia di Salute, Tecnologia, Comunicazione e Business, fanno parte del personale docente di TECH.
Un metodo di apprendimento unico
TECH è la prima università ad utilizzare il Relearning in tutte le sue qualifiche. Si tratta della migliore metodologia di apprendimento online, accreditata con certificazioni internazionali di qualità docente, disposte da agenzie educative prestigiose. Inoltre, questo modello accademico dirompente è integrato con il "Metodo Casistico", configurando così una strategia di insegnamento online unica. Vengono inoltre implementate risorse didattiche innovative tra cui video dettagliati, infografiche e riassunti interattivi.
TECH combina il Relearning e il Metodo Casistico in tutti i suoi programmi universitari per garantire un apprendimento teorico-pratico di eccellenza studiando quando e da dove vuoi.
La più grande università digitale del mondo
TECH è la più grande università digitale del mondo. Siamo la più grande istituzione educativa, con il migliore e più ampio catalogo educativo digitale, cento per cento online e che copre la maggior parte delle aree di conoscenza. Offriamo il maggior numero di titoli di studio, diplomi e corsi post-laurea nel mondo. In totale, più di 14.000 corsi universitari, in undici lingue diverse, che ci rendono la più grande istituzione educativa del mondo.
TECH possiede il più ampio catalogo di programmi accademici e ufficiali al mondo, disponibile in oltre 11 lingue.
Google Partner Premier
Il gigante americano della tecnologia ha conferito a TECH il logo Google Partner Premier. Questo premio, accessibile solo al 3% delle aziende del mondo, conferisce valore all'esperienza efficace, flessibile e adattata che questa università offre agli studenti. Il riconoscimento non solo attesta il massimo rigore, rendimento e investimento nelle infrastrutture digitali di TECH, ma fa anche di questa università una delle compagnie tecnologiche più all'avanguardia del mondo.
Google ha posizionato TECH tra il 3% delle più importanti aziende tecnologiche del mondo, conferendogli il suo loro Google Partner Premier.
L’università online ufficiale dell’NBA
TECH è l'università online ufficiale dell'NBA. Grazie ad un accordo con la più grande lega di basket, offre ai suoi studenti programmi universitari esclusivi, nonché una vasta gamma di risorse educative incentrate sul business della lega e su altre aree dell'industria sportiva. Ogni programma ha un piano di studi di design unico e presenta relatori ospiti eccezionali: professionisti con una distinta carriera sportiva che offriranno la loro esperienza nelle materie più rilevanti.
TECH è stata riconosciuta dall'NBA, la più importante lega di basket del mondo, come sua università online ufficiale.
L'università meglio valutata dai suoi studenti
Il sito di valutazione Global score ha posizionato TECH come l'università più apprezzata al mondo dai suoi studenti. Questo portale di recensioni, il più affidabile e prestigioso perché verifica e convalida l'autenticità di ogni opinione pubblicata, ha assegnato a TECH la sua valutazione più alta, 4,9 su 5, sulla base di oltre 1.000 recensioni ricevute. Cifre che rendono TECH un riferimento universitario assoluto a livello internazionale.
TECH è l'università meglio valutata al mondo dai suoi studenti.
Leader nell'occupabilità
TECH è riuscita a diventare l'università leader nell'occupabilità. Il 99% dei suoi studenti ottiene un lavoro nel campo accademico che hanno studiato, prima di completare un anno dopo aver terminato uno qualsiasi dei programmi universitari. Una cifra simile riesce a migliorare la propria carriera professionale immediatamente. Tutto questo grazie ad una metodologia di studio che basa la sua efficacia sull'acquisizione di competenze pratiche, assolutamente necessarie per lo sviluppo professionale.
Il 99% degli studenti di TECH ottiene il lavoro a cui aspira nel primo anno dopo aver completato gli studi.
Corso Universitario in Parassitologia nell’Industria Alimentare
La parassitologia è una branca della biologia che studia i parassiti e la loro relazione con i loro ospiti. Nell'industria alimentare la Parassitologia è fondamentale per garantire la sicurezza e la qualità degli alimenti che consumiamo. Il Corso Universitario in Parassitologia nell’Industria Alimentare ti permetterà di acquisire le conoscenze necessarie per comprendere le diverse tipologie di parassiti che possono contaminare gli alimenti e come prevenirne la comparsa.
Durante il corso imparerai i metodi di rilevamento dei parassiti e come eseguire un'analisi dei rischi per minimizzarne la presenza nell'industria alimentare. Imparerai anche a conoscere le malattie che i parassiti possono trasmettere attraverso il cibo e le misure preventive che possono essere prese per prevenirne la diffusione. Questo corso è ideale per coloro che sono interessati a lavorare nel settore alimentare o in settori legati alla salute pubblica e alla sicurezza alimentare.
Sviluppa la tua carriera nell'industria alimentare con il Corso Universitario in Parassitologia nell’Industria Alimentare
L'industria alimentare è una delle più importanti al mondo e la domanda di professionisti qualificati in questo settore continua ad aumentare. Il corso universitario in Parassitologia nell’Industria Alimentare è un'ottima opportunità per sviluppare le tue capacità e conoscenze in un'area chiave di questo settore. Al termine del corso sarai in grado di identificare e prevenire la presenza di parassiti negli alimenti, fondamentale per garantire la sicurezza alimentare e la salute pubblica.
Inoltre, con il Corso Universitario in Parassitologia nell’Industria Alimentare potrai migliorare il tuo profilo professionale e aumentare le tue opportunità occupazionali nel settore alimentare. Questo programma di formazione ti fornirà una specializzazione completa in parassitologia, permettendoti di distinguerti come esperto nel campo della sicurezza alimentare e della salute pubblica. Non perdere l'opportunità di sviluppare la tua carriera nell'industria alimentare e unisciti ora a questo corso di parassitologia!







